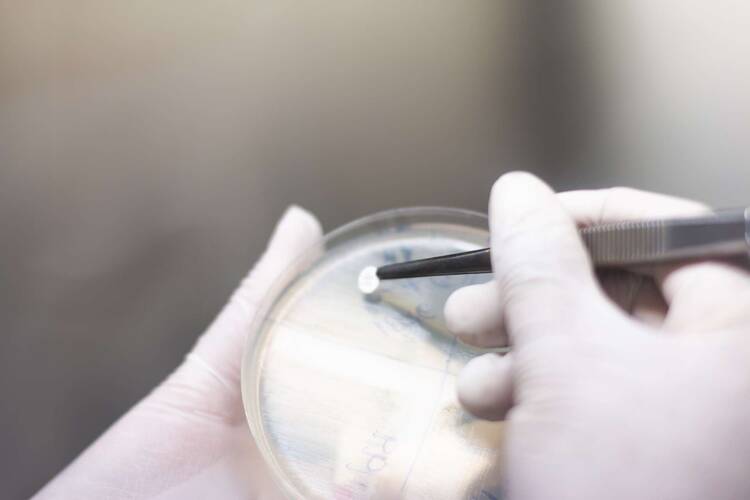

Ratgeber Smartphone Bakterien auf dem Handy: So gefährlich können Keime werden
Keime sind ein wesentlicher Bestandteil unseres Lebens und bleiben doch komplett verborgen. Naja, meistens jedenfalls. Sichtbar werden Bakterien bzw. ihre Folgen dann, wenn sie zu Krankheiten führen. Aus diesem Grund ist es wichtig, dass wir uns und unsere Umgebung möglichst sauber halten. Dazu gehört es zu duschen, Hände zu waschen, die Wohnung zu putzen und Alltagsgegenstände, wie unser Geschirr, die Brille oder den Spiegel zu reinigen. Was dabei jedoch allzu gerne vergessen wird, ist das eigene Smartphone. Eigentlich komisch, denn kaum einen Gegenstand verwenden wir öfter als unser Telefon. Wie gefährlich können Bakterien auf Handy-Oberflächen werden und wie oft sollten Sie Ihr Smartphone putzen? Wir verraten es Ihnen.
Bakterien auf dem Handy – so schnell kann’s gehen
Unser Smartphone ist ständig in Benutzung. Dass dadurch die Wahrscheinlichkeit steigt, dass Bakterien auf Handy bzw. Display gelangen, ist also relativ hoch. Es ist somit nicht verwunderlich, dass Bakterien auf Handy-Oberflächen die Ausnahme und nicht die Regel bilden. Eine der häufigsten Ursachen dafür, ist die Benutzung im Bad. Wer hat das Smartphone nicht schon einmal mit auf Toilette genommen, hat die Abendnachrichten beim Zähneputzen gelesen oder sich zum Duschen eine Playlist angemacht. Besonders in diesen Situationen ist die Chance äußerst hoch, dass sich Bakterien auf Handy, Backcover und Bildschirm breit machen. Warum das so ist, kann schnell erklärt werden.
Im Badezimmer befinden sich die Bakterien, die sich auf unserer Haut und in unserem Darm befinden. Wenn Sie Ihr Smartphone mit ins Bad nehmen, legen sich genau diese Keime auf Ihr Telefon. Hierzu zählen beispielsweise Bakterien wie E.coli, die sich im Darm befinden. Der einfachste Weg, wie sich E.coli Bakterien auf Handy-Oberflächen tummeln, ist über unsere Hände, nachdem wir auf der Toilette waren. Der Mensch besitzt zehnmal mehr Bakterien auf der Haut, als er Zellen im Körper hat. Je mehr wir uns Bakterien aussetzen, insbesondere im Badezimmer, desto mehr werden die Bakterien, die uns täglich umgeben. Es ist also darauf zu achten, dass Sie Ihr Smartphone vor der Toilettentür lassen.
Zusammengefasst lässt sich sagen: Das Problem mit der Hygiene, dem Smartphone und dem Badezimmer sind nicht die Telefone selbst. Die eigentliche Schwierigkeit liegt an einem Mangel an Sauberkeit. Wenn Sie dafür sorgen, dass Sie sich regelmäßig die Hände waschen, ganz besonders nachdem Sie auf der Toilette waren und auch Ihr Handy täglich von Keimen befreien, minimieren Sie die Gefahr von Bakterien auf Handy-Oberflächen. In Zeiten von Corona und Lockdown haben wir uns zwar schon dran gewöhnt, oft die Hände zu waschen. Mit Hinblick auf Bakterien auf Handy und Display, sollte dies jedoch auch ohne Pandemie zu einer regelmäßigen Gewohnheit werden.
Sind Bakterien auf Handy-Oberflächen schädlich?
Die gute Nachricht zu Beginn: Bakterien auf Handy-Oberflächen sind grundsätzlich nicht schädlich. Das, was sie vor allem sind, ist eklig. Besonders, wenn Sie sich nach dem Toilettengang nicht die Hände gewaschen haben, gelangen Keime in Windeseile auf Ihr Smartphone. Telefonieren Sie anschließend damit oder kratzen sich auch ohne Handy an der Nase, habe Sie die Keime im Gesicht. Bakterien sind grundsätzlich nichts Schlechtes, der Alltag ist voll damit. Unser Immunsystem ist in der Regel gegen die meisten Keime gewappnet. Bakterien auf Handy-Displays sind damit nicht unbedingt schädlich, aber definitiv eklig und sollten so gut es geht vermieden werden.
Die Elektrogerätversicherung von WERTGARANTIE
Schützen Sie jetzt Ihr Lieblingsgerät und genießen Sie folgende Vorteile einer Elektroversicherung:
- Schutz vor Schäden aller Art und Diebstahl
- Schneller und unkomplizierter Service im Schadenfall
- Niedriger Monatsbeitrag gegenüber teuren Reparaturen oder Neuanschaffungen

Gibt es gefährliche Bakterien auf Handy-Oberflächen?
Obwohl Bakterien auf Handy, Display und Backcover in erster Linie unhygienisch sind, gibt es trotzdem Keime, die durchaus eine Gefahr für Sie darstellen können. Zu diesen zählen insbesondere Bakterien aus Krankenhäusern. Gehen Sie dort auf eine öffentliche Toilette, besteht durchaus eine Gefahr, dass sich dort resistente Keime auf Ihrem Smartphone Platz machen. Diese können tatsächlich ein Problem für Ihre Gesundheit darstellen. Es empfiehlt sich daher Ihr Handy nicht in einer öffentlichen Krankenhaus Toilette zu zücken, um die Zeit zu überbrücken. Achten Sie grundsätzlich darauf, dass Sie Ihr Handy regelmäßig und besonders nach Besuchen im Krankenhaus reinigen.
Bakterien auf Handy und Display richtig entfernen
Möchten Sie, dass Bakterien auf Handy-Oberflächen der Vergangenheit angehören, dann sollten Sie Ihr Telefon regelmäßig reinigen. Achten Sie darauf, dass Sie dabei auf chemische Reiniger verzichten. Die können nämlich nicht nur dem Smartphone, wie z.B. dem Touchscreen, schaden, sondern auch Ihnen. Greifen Sie stattdessen lieber auf Produkte zurück, die speziell für das Reinigen von Smartphones entwickelt wurden. Alltagsmittel, die Sie einfach auftreiben können bzw. griffbereit haben, sind Wattestäbchen. Damit lassen sich super kleine Ritzen und Anschlüsse von Keimen und Schmutz befreien. Feuchten Sie dazu das Wattestäbchen leicht an und beginnen mit dem Reinigen.
Knetmasse ist ein weiteres Mittel, dass super gegen Bakterien hilft. Im Internet finden Sie bereits für wenig Geld sogenannte „antibakterielle Reinigungsmassen“. Sollten Sie nach einem professionellen Reinigungsmittel suchen, das Schmutz sowie Bakterien auf Handy bzw. Display entfernt, dann ist Knetmasse ein effektiver Weg. Zum Klassiker der Reinigungsutensilien zählt das Mikrofasertuch. Brillenträger besitzen ohnehin eines, ansonsten können Sie dieses für einen geringen Preis online finden. Die meisten Hersteller von Displayfolien schicken bei Bestellung ein, zwei Tücher gratis mit. Damit lässt sich Ihr Smartphone, insbesondere das Display schnell und gründlich reinigen.
Mit Zahnstochern lassen sich zwar keine Bakterien auf Handy Oberflächen entfernen, dafür aber Schmutz und kleinere Krümel. Besonders für die kleinen Zwischenräume, die es auf einem Telefon gibt, z.B. zwischen Display und Backcover, ist der Zahnstocher das ideale Mittel. Es gibt viele Möglichkeiten, wie Sie Ihr Smartphone sowohl von Keimen als auch von Dreck im Allgemeinen befreien können. Einen ausführlichen Artikel darüber, wie Sie Ihr Telefon bakterien- und schmutzfrei machen und welche Mittel Sie dafür am besten verwenden, können Sie hier nachlesen: Smartphone reinigen: So machen Sie es richtig sauber.












